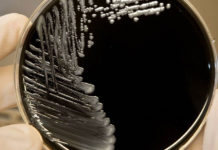
Legionella: hace casi una década la UNNE viene estudiándola y alerta sobre la importancia de estudios epidemiológicos

Argentina lanza Campaña Nacional de Vacunación contra sarampión, rubéola, paperas y poliomielitis con apoyo...
Con el objetivo de reforzar la protección de la...
Oncología: biopsia líquida, la herramienta que permitirá cronificar el cáncer
El director del grupo de investigación Oncomed del Hospital...
Determinaron que el bótox afecta el control sensorial en el cerebro
Según un estudio, esta toxina produce la interrupción de...
Avena, el superalimento que ayuda a conciliar el sueño y a fortalecer el cerebro
Aporta fibra, vitamina, mineral y proteína, lo que contribuye...
Día Mundial de la Fibrosis Quística: ¿cómo se presenta la enfermedad?
El 8 de septiembre se celebra el Día Mundial...
Un análisis de sangre podría detectar cáncer antes de que aparezcan síntomas
Los oncólogos participantes en la investigación subrayan la importancia...
El embudo de agotamiento y el síndrome de burn out
Demanda continua, expectativas inalcanzables, exigencias incesantes. Esta es la...
El Hospital Garrahan desarrolló y produjo medicamentos magistrales para bebés con VIH
El área de Farmacia del establecimiento produjo medicamentos destinados...
Trastorno bipolar: algo más que solo un cambio de humor
La bipolaridad se caracteriza por cambios extremos en el...
Legionella: hace casi una década la UNNE viene estudiándola y alerta sobre la importancia...
Desde el año 2014 el Instituto de Medicina Regional...